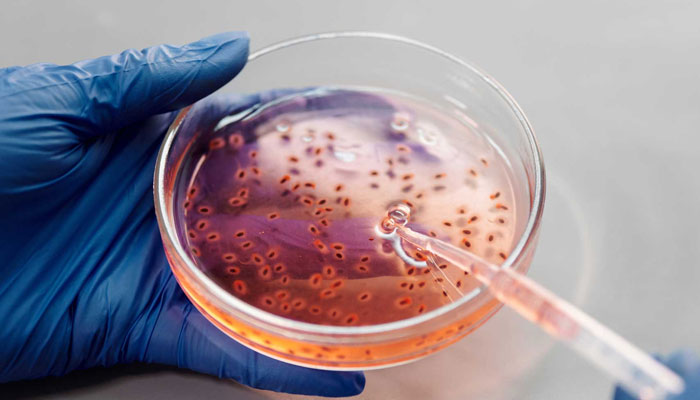

An innovative system for monitoring chromosomal fragility and copy number alterations in particularly lethal tumours was described earlier this July by researchers from Cambridge University and the National Cancer Research Center in Madrid. Researchers believe this is the first time a system has been developed to comprehend the function of internal variables in triggering such genetic mutations after analysing over 8,000 tumours from 33 different malignancies.
A different group of Cambridge researchers employed whole genome sequencing in the same area to map the biggest sample of mutational signatures to date. The researchers discovered 58 brand-new signatures and created a computer programme to aid oncologists in identifying these patterns in specific patients.
Over the years, genomic research has significantly increased the knowledge of disease pathogenesis. But considering the variety of samples utilised and the many approaches researchers have taken to overcome issues, the recent wave of research papers has stood out. But even while these new discoveries deepen the understanding of how genetic changes and specific mutations may contribute to cancer, it is still difficult to apply them to guide therapeutic use.
Similar broad objectives, but various approaches
By examining copy number signatures from various malignancies, Florian Markowetz, PhD, and his colleagues discovered 17 different types of chromosomal fragility and 49 brand-new therapeutic targets. The group concentrated on a particular subset of tumours that commonly exhibit high levels of chromosomal instability, or high-risk indicators. According to Markowetz, who is himself a senior group leader at Cancer Research UK Cambridge Institute, the genomes of these malignancies can have complete chromosomes missing or doubled and folded instead of just two copies.
Researchers from Cambridge University Hospitals, under the direction of Dr. Serena Nik-Zainal, reported their findings on mutational signatures from the largest study of its kind in a separate publication. The team examined 12,222 samples gathered as part of the 100,000 Genomes Project’s whole genetic sequencing efforts by the UK National Health Service and added more information on 6,418 cancer cases.
Similar objectives were shared by both teams. In a summary, Markowetz claims that their study examined mutations in a cancer genome that were drawn from the Cancer Genome Atlas of the US National Cancer Institute. However, although Markowetz and colleagues looked at considerably larger copy number changes, Nik-Zainal’s study focused mostly on single-base and double-base substitutions. Markowetz explains that although both the investigations sought to identify the causes of the mutations, the information and methodologies that were used varied.
Geoff Macintyre, PhD, junior group leader at the Spanish National Cancer Institute, says that Nik-Zainal’s research looks at point mutations, which are often caused by things outside of the cell. Most causes of chromosomal instability are endogenous, meaning they come from inside the cell.
Understanding point mutations can help understand how cancerous mutations form. However, researchers in Nik-Zainal’s study examined both types of alterations: cancer-causing mutations as well as passenger mutations. According to Andrea Degasperi, PhD, a research associate at Cambridge University’s Early Cancer Institute and Department of Medical Genetics who was involved in the study, when one looks at these malignancies, one can begin to notice patterns. They suggest that something occurred in the past to cause these mutations, which may have been a result of environmental hazards. Nevertheless, he continues, some patterns are more recent and particular to the cancer cell.
According to Degasperi, these patterns provide a very specific genomic portrait of each disease by giving hints on the mechanisms causing mutations, such as internal DNA repair system flaws that result in internal mutations or external dangers like UV light or smoking. In the future, this knowledge may be applied to better treatment, the creation of new drugs, and the identification of the influence of environmental factors on the development of cancer.
There is room for drug development, exploration, and repurposing
According to Degasperi, emphasis on internal variables that cause genomic instability offers the chance to develop medications that work in harmony with DNA mismatch repair and are less hazardous to healthy cells. However, this method can even be utilised to more precisely exploit treatments that are already accessible. According to Markowetz, copy number variations can be used as biomarkers to identify the effectiveness of therapy in various patients.
The article in Nature discusses this in relation to chemotherapy based on platinum. According to Markowetz, copy number variations can be utilised to distinguish between patients who react to platinum chemotherapy and those that don’t.
Macintyre says, some of the pharmacological targets found in the Nature study are brand new, and pertinent treatments will probably emerge within the next 10 years. Other targets, however, already have medicines in the early stages of development, which may make early drug development more effective, he claims.
According to Macintyre, the use of copy number variations is particularly important since it may be used to find medication targets that are effective against a variety of tumours, setting it apart from other precision medicines that frequently focus on gene mutations. He argues that they are constrained by the precision and patient population, whereas copy number alterations may assist larger patient populations.
At the Cambridge subsidiary, Tailor Bio, Markowetz and Macintyre are currently using this technique to create novel medicines. The startup, according to Markowetz, the technical head, is currently raising seed money. According to Degasperi, the Nik-Zainal study was able to identify new signs, many of which are uncommon, due to the high number of sequenced samples. Some people might benefit from this, he continues, even if only a small number of these uncommon mutational signatures indicate an effective treatment for a particular illness.
Indeed, according to Professor of Genetics at Stanford University, Michael Snyder, PhD, concentrating on mutational burden is crucial for studies connected to cancer and tailored treatment. High mutational loads can now be used to predict immunotherapy responses. According to Snyder, it may one day be used to create tailored cancer vaccinations, some of which are based on extremely precise sequences. But he also asserts that the creation of medications using these techniques will lag behind their application to current treatments.
Concerns about the use of genomic data still exist
But several important issues are still unresolved. According to Degasperi, many mutational signature patterns’ origins are still unclear. The proper medicine can be found, he says, if certain of these characteristics are caused by particular DNA repair errors that can be replicated in the lab.
An algorithm called Signature Fit Multi-Step, created by Degasperi and his colleagues, can recognise both common and uncommon signatures. He identifies the need for such infrastructure development as a challenge that calls for financial commitment, training, and perhaps even regulation in the area of data safety.
According to Macintyre, similar difficulties arise when attempting to identify and quantify the causes of chromosomal instability. He notes that while some of these changes are happening and would be preferable to target, others could have occurred 20 years ago and have no therapeutic relevance. In this sense, single-cell whole genetic analysis would be necessary to distinguish between the two.
Accessing research funding for such cancer-agnostic techniques, which are less desirable to potential investors, might be difficult because it is frequently focused on single-target approaches. Inspite of the fact that getting this financed demands a shift in attitude for venture capital and investors, and that is a huge barrier, he claims, they have a very broad system that has the ability to work across cancer kinds and for various medications.